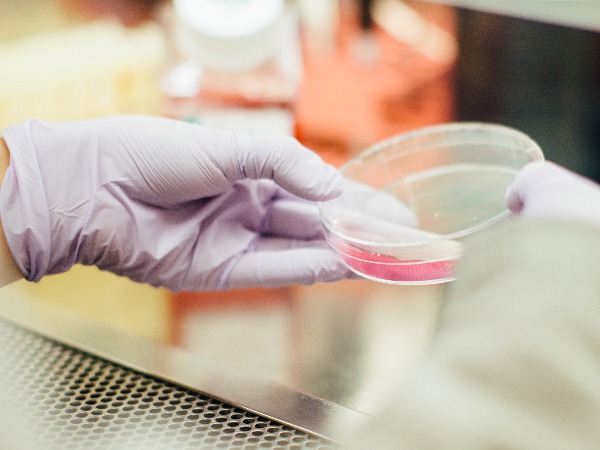
图片侵权_专利代理师_代理中心

≥▽≤最近9天内网友在关注#专利代理师#新闻报道汇总,日前,的相关内容时,访问最多的图文热点内容!在浏览或检索专利代理师相关信息时,关注度较高的50个站内链接。亿佰倍懂商标的编辑个人员在整理信息时为了方便查阅给对应链接做了编号,编号顺序不代表相关度排名。跟关键词:专利代理师相关性不大,但在最近10小时内被大量检索并关注的话题。当日时间!!
核心提示:专利代理师
简介专利代理师的相关数据,网友关注的专利代理师标签,提供更多可参考资料,包括但不限于专利代理师相关的 图文选集 。作者:重磅。
上一篇:产品外观侵权_国家专利网查询入口_费用
下一篇:图片侵权_专利代理师_代理中心
便捷链接:外观,专利申请,版权,申请,价格,低至,1元,核心,
本文来源:网络?买卖商标注册授权入驻“天猫”“京东”“拼多多”“抖音头条”“商标百科”
版权说明:上述为转载或编者观点,不代表亿佰倍懂商标意见,不承当任何法律责任
亿佰倍懂商标官方微信
欢迎关注亿佰倍懂
微信号:K58158 热门TAGS
酒类商标转让 衬衫商标转让 转让33类商标 底价商标转让 商标转让营业 购买白酒商标 白酒类商标 酱酒商标转让 狙击手电影院 四海电影院 注册商标查询 中国白酒商标 logo商标 酒商标名字 粮食酒商标 以牛取商标名 商标代理转让 剑南春产值2022 白金价格 卡斯特红酒 五粮液价格表 茶叶商标大全 商标注册申请 酒的商标申请 独特商标名字 商标取名网 品牌商标名字 商标分类表 酒的商标设计 酒名商标 著名商标图片 个人注册商标 商标设计图 商标名称推荐 商标转让入驻 商标转让流程 商标转让网 闲置商标转让 商标转让核准 商标转让印花 中派商标转让 大牌商标 白酒商标 纯粮酒商标 商标买卖 怎样注册商标 商标图案大全 品牌商标logo 测算商标 酒的商标 好名字商标 有创意的商标 商标超市 免费设计商标 商标名字 商标名称 酒的商标名字 范思哲商标 5年3年商标被驳 欧洲商标买卖
联系方式
【商标网】
企业QQ:1728988888
手机: 18211558558
官方微信:K58158
广东(总部)北京(分部)深圳(分部)

*截止
,共有人阅读了本文。

用户评论










40
加工服务
注:网友评论仅供其表达个人看法,并不代表本站立场。